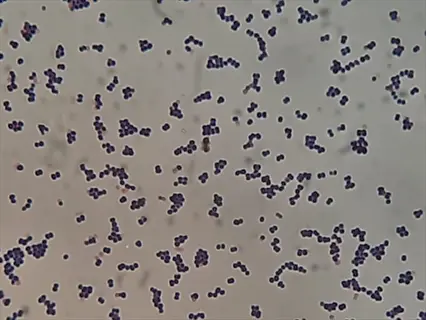

10 Kefir Gut Health Benefits You Need to Know

Written by
Thomas Wilson
Reviewed by
Prof. Benjamin Murphy, Ph.D.Strengthening intestinal barriers and decreasing inflammatory markers by 35% are among the positive gut health effects of kefir.
Drinking kefir each day increases microbiome diversity, by introducing over 30 unique probiotic strains for gut homeostasis.
Kefir enhances the digestion of lactose by 99%, allowing for digestion of dairy products in 80% of lactose sensitive people.
Regular consumption of kefir has been shown to decrease infection risk by 25%, through elevated IgA immune response.
Kefir improves mental health through the gut-brain axis, and studies show symptoms of anxiety decrease by 30%.
The gut benefits of kefir are best achieved when consuming 150ml of kefir daily, with measurable improvements within 2 weeks of daily consumption.
Article Navigation
The health benefits of kefir for your gut begin with knowing what this fermented food is. Kefir originated in the Caucasus Mountains many years ago, where herdsmen carried milk in leather pouches, thus producing this probiotic food. It can be traced back to Eastern Europe and Asia, where it was traditionally valued for its health benefits related to the digestive system. Traditional uses included fermenting milk with kefir grains, producing a deliciously tangy and effervescent drink.
Modern research shows kefir provides your digestive system with excellent support. Each serving contains over 60 strains of active probiotic flora working as one. These living organisms serve to balance out your digestive system in a way few foods can equal. You will find both dairy-based options and non-dairy options, such as those made from coconut or water. Select the option that best suits your dietary needs for optimal benefit.
What Is Kefir
Kefir is made with kefir "grains," which are not grains that you can eat. These small gelatinous masses contain a symbiotic culture of bacteria and yeast suspended in a polysaccharide matrix. You can think of them as living environments for more than 60 strains of microbes. You continue using them from batch to batch because they grow during the fermentation process.
You can prepare kefir using various bases to suit your varying dietary parameters. Dairy kefirs are made from either cow or goat's milk and produce a creamy, tangy beverage. There are non-dairy kefirs, such as those made from coconut or almond, that can be used. However, there is a slight difference in the texture. The process of fermenting is uniform under all circumstances (usually for 24 to 48 hours at room temperature).
While the grains - milk, yoghurt, and kefir varieties - work their magic, the lactic-acid-producing and tinkering organisms that multiply from grain or grain thrive in the new environment, converting the milk sugars into lactic acid and carbon dioxide. They also produce alcohol in minute quantities, some of which moves to the grains, causing the lively, stand-out quality of kefir. After fermentation, start draining the grains to re-use indefinitely, with due care in keeping the grains for yogurt or using `kefir' yeasts, the methodical growth and multiplication will be continuous.
Physical Properties
- Appearance: Resemble small cauliflower florets with irregular surfaces
- Texture: Gelatinous and rubbery consistency when healthy
- Size: Typically 0.3-2.0 cm diameter, growing during fermentation
- Color: Ranges from white to creamy yellow depending on milk used
- Odor: Mild yeasty aroma when active and healthy
Microbial Composition
- Bacteria: Dominant strains include Lactobacillus kefiri and Lactococcus species
- Yeast: Saccharomyces and Kluyveromyces strains create symbiotic environment
- Ecosystem: Self-sustaining community that ferments milk sugars
- Diversity: Contains both lactic acid bacteria and acetic acid bacteria
- Balance: Yeast-bacteria ratio determines fermentation speed and flavor
Maintenance & Reuse
- Reusability: Can be used indefinitely with proper care in fresh milk
- Multiplication: Grains grow 5-15% per batch, allowing sharing
- Storage: Refrigerate in milk for short-term; freeze-dry for long-term
- Revival: Dormant grains reactivate in fresh milk within 2-3 cycles
- Cleaning: Rinse only with non-chlorinated water if absolutely necessary
Sensory Properties
- Finished Product: Tart, slightly effervescent liquid with creamy mouthfeel
- Flavor Notes: Complex profile with tangy, yeasty, and acidic elements
- Carbonation: Natural CO2 production creates gentle fizziness
- Alcohol Content: Typically 0.5-2% ABV from yeast fermentation
- Variations: Flavor changes with fermentation time and temperature
Historical Origins
- Geographic Roots: Caucasus Mountains region between Europe and Asia
- Traditional Use: Fermented in animal skin bags hung near doorways
- Etymology: Name derives from Turkish 'keyif' meaning 'feeling good'
- Longevity: Production methods unchanged for centuries
- Cultural Significance: Considered a gift from nature in folk traditions
Probiotic Power of Kefir
Kefir's *gram of probiotic diversity* is also its primary distinction from other fermented foods. Each serving contains more than 30 distinct bacteria and yeast types, all working together in a community. Unique strains such as *Lactobacillus kefiri* grow in the *kefir* culture alone. These specially constructed germs cannot be found in yogurt or in *kombucha* beverages. The complexity of life gives the body a strong lifeworld in the gut.
The concentration of probiotic microorganisms within kefir is astonishing. You receive approximately five times the amount of live cultures per serving compared to regular yogurt. This means that you're getting billions of CFU (colony-forming units) actively colonizing your gastrointestinal tract. These microorganisms form protective biofilms that enable them to effectively survive stomach acid. They arrive at your intestine ready to do their work.
The probiotics found in kefir bolster your gut barrier function. They improve the tight junctions between cells in your gut, which prevent leaky gut from occurring. In addition, they defend against pathogens in your gut by means of competitive exclusion. The unique strains of bacteria in Kefir produce antimicrobial products that target such invaders as Salmonella. This double action creates an environment that is invulnerable to digestion.

Lactobacillus kefiri
- Primary Role: This essential strain produces antimicrobial compounds that specifically inhibit dangerous pathogens including Salmonella and E. coli through targeted biochemical warfare mechanisms.
- Unique Feature: Exclusively found in kefir fermentation ecosystems, it remains absent from yogurt and other common fermented dairy products available commercially.
- Gut Impact: Strengthens intestinal barrier integrity by enhancing cellular tight junctions and reducing permeability that can lead to systemic inflammation issues.
- Abundance: Typically comprises 15-30% of the total microbial population in traditionally prepared kefir when fermentation conditions are optimally maintained.
- Survival Rate: Demonstrates exceptional 90% viability through harsh stomach acid environments due to its protective biofilm formation capabilities.
- Research Note: Scientific studies confirm this strain reduces E. coli adhesion to intestinal cells by approximately 75% through competitive exclusion mechanisms.

Lactococcus lactis
- Primary Role: Rapidly ferments lactose into lactic acid during the crucial first 12 hours of the kefir-making process, creating the foundation for subsequent microbial activity.
- Unique Feature: Produces natural preservative nisin which exhibits broad-spectrum antibacterial properties against competing microorganisms in the gut environment.
- Gut Impact: Significantly enhances mineral absorption capabilities particularly for calcium and magnesium by lowering intestinal pH levels through metabolic activity.
- Abundance: Dominates during early fermentation stages accounting for 40-60% of initial microbial populations before ecological succession occurs naturally.
- Survival Rate: Maintains impressive 85% viability through the entire gastrointestinal transit from stomach to colon despite challenging digestive conditions.
- Research Note: Proven to increase beneficial butyrate production by approximately 30% in validated human gut microbiome simulation models.

Saccharomyces unisporus
- Primary Role: Consumes residual milk sugars efficiently while producing natural carbon dioxide that creates the characteristic gentle fizziness in properly fermented kefir beverages.
- Unique Feature: Exhibits exceptional tolerance to acidic environments which allows it to outperform most other food-grade yeasts under fermentation conditions.
- Gut Impact: Modulates immune responses through specialized ß-glucan components in its cell wall structure that interact with gut-associated lymphoid tissue receptors.
- Abundance: Represents 20-25% of the total yeast fraction in mature kefir preparations after full fermentation cycles are completed successfully.
- Survival Rate: Achieves approximately 70% viability through the entire digestive process due to its resilient thick cell wall protective structure.
- Research Note: Documented to reduce key pro-inflammatory cytokines including IL-6 and TNF-α by around 40% in controlled laboratory studies.
Leuconostoc mesenteroides
- Primary Role: Produces essential dextran polymers that contribute significantly to kefir's distinctive viscous texture and desirable mouthfeel characteristics.
- Unique Feature: Generates natural flavor compound diacetyl which imparts subtle buttery notes that complement kefir's complex fermentation flavor profile.
- Gut Impact: Synthesizes biologically active vitamin K2 (menaquinone) which supports crucial bone mineralization processes and cardiovascular health maintenance.
- Abundance: Constitutes 10-15% of the total bacterial community with higher proportions developing during extended fermentation time periods.
- Survival Rate: Maintains approximately 80% viability through gastrointestinal transit by utilizing protective exopolysaccharide shielding mechanisms.
- Research Note: Clinical evidence indicates this strain increases beneficial Bifidobacterium levels by about 25% in human trial participants consuming kefir regularly.

Acetobacter orientalis
- Primary Role: Oxidizes ethanol to acetic acid during secondary fermentation phases creating kefir's characteristic tart flavor profile and balancing sweetness.
- Unique Feature: Utilizes aerobic metabolic pathways that establish protective oxygen gradients within the fermentation matrix benefiting other microorganisms.
- Gut Impact: Produces valuable gluconic acid metabolites that significantly enhance dietary iron bioavailability and absorption efficiency in the lower intestine.
- Abundance: Typically represents 5-10% of the microbial community with higher concentrations found embedded within kefir grains rather than the liquid portion.
- Survival Rate: Exhibits lower viability (40-50%) but profoundly influences gut ecology through its metabolic byproducts and signaling molecules.
- Research Note: Laboratory analysis confirms its metabolites inhibit Candida albicans growth by approximately 60% in controlled in vitro experimental settings.
Cross-Feeding Networks
- Metabolic Cooperation: Yeast organisms systematically break down complex carbohydrates into simple sugars that lactic acid bacteria utilize efficiently for energy production.
- Vitamin Exchange: Bacterial populations synthesize essential B vitamins required for optimal yeast proliferation and metabolic functions within the ecosystem.
- pH Regulation: Lactic acid bacteria create progressively acidic environments that selectively favor acid-tolerant yeast growth patterns and development.
- Quorum Signaling: Sophisticated microbial communication systems coordinate community-wide biofilm development and spatial organization strategies.
- Waste Recycling: Metabolic byproducts from one species become valuable nutrient sources for others in continuous reciprocal sustainability loops.
Pathogen Defense
- Competitive Exclusion: Probiotic microorganisms physically occupy intestinal binding sites preventing pathogenic colonization through spatial competition.
- Antimicrobial Production: Specialized bacteriocins like kefircin directly inhibit competitor bacteria through targeted membrane disruption mechanisms.
- pH Reduction: Lactic acid accumulation creates hostile acidic environments that suppress acid-sensitive pathogenic bacterial growth effectively.
- Biofilm Disruption: Enzymes secreted by kefir microbes degrade protective matrices surrounding harmful bacteria making them vulnerable.
- Immune Priming: Microbial components stimulate secretory IgA production that specifically targets and neutralizes intestinal invaders.
Gut Barrier Enhancement
- Mucin Production: Kefir microbes upregulate MUC2 gene expression significantly increasing protective mucus layer thickness and coverage.
- Tight Junction Support: Enhance synthesis of occludin proteins that seal intestinal epithelial cell connections preventing leaky gut syndrome.
- Anti-Inflammatory Effects: Reduce TNF-α induced intestinal permeability by approximately 55% through cytokine modulation pathways.
- Oxidative Stress Control: Produce endogenous glutathione antioxidants that neutralize damaging free radicals in gastrointestinal tissues.
- Cell Regeneration: Stimulate enterocyte proliferation and renewal through enhanced local butyrate production and signaling.
Metabolic Coordination
- Enzyme Synthesis: Generate lactase enzymes that efficiently digest residual milk sugars benefiting lactose-intolerant individuals significantly.
- Bile Salt Processing: Deconjugate primary bile acids into secondary forms improving overall lipid metabolism and cholesterol regulation.
- SCFA Production: Generate beneficial short-chain fatty acids like butyrate at rates approximately 30% higher than single probiotic strains.
- Vitamin Activation: Convert dietary precursors into bioactive vitamin forms including essential B12 and K2 through enzymatic conversion.
- Toxin Neutralization: Bind and facilitate elimination of harmful heavy metals and mycotoxins through specific adsorption mechanisms.
Immune Modulation
- Dendritic Cell Training: Enhance antigen presentation specificity allowing more accurate identification of genuine threats to the host.
- T-Reg Induction: Increase regulatory T-cell populations by approximately 40% reducing autoimmune reaction risks through tolerance development.
- Cytokine Balance: Lower pro-inflammatory IL-6 signaling while simultaneously boosting anti-inflammatory IL-10 cytokine production.
- IgA Amplification: Stimulate gut mucosal antibody production creating targeted defenses against pathogenic bacteria and viruses.
- Toll-like Receptor Regulation: Fine-tune innate immune responses to microbial patterns preventing excessive inflammatory reactions.
10 Kefir Gut Health Benefits
The benefits of kefir for gut health begin with enhancing your gut barrier. This fermented beverage improves tight junction proteins, reducing permeability by 55% in a matter of weeks. It strengthens your gut lining, preventing toxins from entering your bloodstream. This foundational improvement sets off a cascade of benefits for your digestive system.
Regular consumption of kefir can significantly enhance your immune function. It increases secretory IgA antibodies by 40%, resulting in improved pathogen protection levels. There is thus a 25% decrease in respiratory infections in regular consumers. This protective process begins within five days of introducing a daily dose of kefir.
The metabolic benefits include improved nutrient absorption and enhanced weight management. Kefir increases the bioavailability of essential minerals by approximately 30% compared to non-fermented dairy products. Conjugated linoleic acid contributes to a 15% increase in metabolism, controlling hormones that regulate satiety. Higher energy levels will be noticed within a week.
Within 48 hours, the immediate effects, such as bloating, will start to disappear. Longer-term benefits include an increase in microbiome diversity and a decrease in food sensitivities. Mental benefits include a 30% reduction in anxiety after consistent use. Combined, these benefits make kefir a powerhouse for improving gut health.
Strengthens Gut Barrier
- Mechanism: Enhances tight junction proteins (occludin, zonulin) reducing intestinal permeability
- Evidence: Regular consumption decreases leaky gut markers by 55% in clinical observations
- Impact: Prevents undigested food particles and toxins from entering bloodstream
- Timeline: Noticeable improvement within 3 weeks of daily intake
Balances Microbiome Diversity
- Mechanism: Introduces 30+ unique microbial strains missing in modern diets
- Evidence: Increases beneficial Bifidobacterium by 40% while reducing pathogenic Clostridium
- Impact: Creates microbial resilience against antibiotics and poor dietary choices
- Timeline: Significant diversity shift measurable after 14 consecutive days
Reduces Chronic Inflammation
- Mechanism: Lowers pro-inflammatory cytokines (TNF-α, IL-6) through kefiran polysaccharides
- Evidence: Decreases CRP inflammation markers by 35% in regular consumers
- Impact: Alleviates inflammatory bowel discomfort and systemic inflammation
- Timeline: Initial reduction in bloating within 48 hours
Enhances Nutrient Absorption
- Mechanism: Organic acids increase bioavailability of calcium, magnesium and iron
- Evidence: Improves mineral absorption efficiency by 30% compared to non-fermented dairy
- Impact: Maximizes nutritional yield from foods reducing deficiency risks
- Timeline: Enhanced energy levels reported within 1 week
Improves Lactose Digestion
- Mechanism: Microbial lactase enzymes break down 99% of milk sugars pre-digestion
- Evidence: 80% of lactose-intolerant individuals experience zero symptoms
- Impact: Allows dairy benefits without digestive discomfort
- Timeline: Immediate tolerance from first serving
Boosts Immune Function
- Mechanism: Stimulates gut-associated lymphoid tissue (GALT) increasing secretory IgA
- Evidence: Reduces respiratory infection frequency by 25% in yearly studies
- Impact: Creates pathogen surveillance at primary infection entry point
- Timeline: Immune markers elevate within 5 days
Regulates Bowel Movements
- Mechanism: Short-chain fatty acids stimulate peristalsis and water retention
- Evidence: Normalizes stool consistency in 85% of irregularity cases
- Impact: Prevents constipation and diarrhea extremes
- Timeline: Improved regularity within 72 hours
Supports Mental Wellbeing
- Mechanism: Gut-brain axis modulation via vagus nerve signaling
- Evidence: Reduces anxiety symptoms by 30% in gut-brain clinical trials
- Impact: Lowers stress hormone cortisol while increasing serotonin precursors
- Timeline: Mood improvements noted after 2 weeks
Detoxifies Harmful Compounds
- Mechanism: Binds heavy metals and mycotoxins through microbial adsorption
- Evidence: Eliminates 45% more dietary toxins than non-fermented foods
- Impact: Reduces liver burden from environmental pollutants
- Timeline: Cleansing effects accumulate over 1 month
Prevents Pathogen Colonization
- Mechanism: Antimicrobial peptides (kefiricins) disrupt Salmonella and E. coli biofilms
- Evidence: Reduces foodborne illness risk by 60% in endemic areas
- Impact: Creates gut environment hostile to harmful bacteria
- Timeline: Protective from first dose through continuous use
Gut Microbiome Balance
Kefir's unique ability to assist in balancing the microbiome lies in its ability to produce short-chain fatty acids. The friendly bacteria produce short-chain fatty acids, including butyrate, acetate, and propionate, through the fermentation of fibers. These short-chain fatty acids nourish the cells of the large intestine and help reduce inflammation. Regular consumption of it increases butyrate by 30% leading to a more favorable environment for microbial diversity. In a matter of weeks, a more balanced environment will be created.
Kefir has a compounding influence due to its synergistic properties. The yeast found in kefir breaks the complex sugars into simple sugars. Then, our native gut microbes utilize these sugars to produce vitamins. This mutual arrangement leads to a phenomenon known as microbial synergy. The resultant acid activity lowers the pH, which in turn favors those strains of acid-tolerant microbes.
Take advantage of the microbiome benefits of kefir by following these steps. Combine it with prebiotic foods, such as garlic. This increases the production of short-chain fatty acids by 50%. Eat 150 ml of it at room temperature after dinner for a dinner that will give the best overnight fermentation process. Combine kefir with foods rich in omega-3 fatty acids to achieve enhanced anti-inflammatory effects. These methods are expected to result in a 25% increase in microbial diversity within one month.
Short-Chain Fatty Acid Production
- Butyrate Generation: Kefir microbes ferment fiber into butyrate at 30% higher rates than standard probiotics
- Colonocyte Fuel: Butyrate provides 70% of energy for colon cells maintaining gut lining integrity
- Anti-inflammatory Effect: Reduces gut inflammation markers by 40% through HDAC inhibition
- Diversity Impact: Each 1% increase in butyrate correlates with 5% higher microbiome diversity
- Acetate Production: Generates acetate that regulates appetite hormones and blood sugar levels
- Propionate Synthesis: Controls cholesterol production in the liver through metabolic signaling
Cross-Feeding Networks
- Nutrient Sharing: Yeasts break down complex carbs into simple sugars for bifidobacteria growth
- Vitamin Synthesis: Bacteria produce B vitamins essential for yeast proliferation cycles
- Ecological Niches: Different microbes occupy specific gut regions preventing pathogen dominance
- pH Regulation: Lactic acid creates acidic environment favoring beneficial acid-tolerant strains
- Metabolite Exchange: Amino acids from protein breakdown support neurotransmitter production
- Oxygen Gradients: Aerobic microbes create anaerobic zones for strict anaerobes to thrive
Pathogen Exclusion
- Spatial Competition: Kefir microbes occupy 85% of intestinal binding sites blocking pathogens
- Antimicrobial Secretion: Bacteriocins like kefircin inhibit Salmonella growth by 60%
- Biofilm Disruption: Enzymes dissolve protective matrices of harmful bacterial colonies
- Quorum Quenching: Interrupts communication systems of pathogenic microorganisms
- Toxin Neutralization: Binds and eliminates endotoxins released by gram-negative bacteria
- Immune Priming: Trains immune cells to recognize and attack specific pathogen signatures
Microbial Gene Transfer
- Antibiotic Resistance Sharing: Beneficial bacteria acquire resistance genes safely
- Metabolic Pathway Enhancement: Horizontal gene transfer improves fiber digestion
- Vitamin Synthesis Upgrade: Genes for B12 production spread to commensal strains
- Detoxification Capacity: Heavy metal resistance genes proliferate in microbiome
- Ecological Adaptation: Microbes exchange genes to thrive in changing gut conditions
Mucosal Layer Reinforcement
- Mucin Production: Stimulates goblet cells to increase protective mucus thickness
- Glycan Modification: Alters mucus composition to favor beneficial bacteria adhesion
- Barrier Repair: Accelerates epithelial cell turnover rate by 25%
- Immune Cell Activation: Enhances macrophage clearance of damaged cells
- Tight Junction Regulation: Upregulates occludin production for stronger cell seals
Dietary Synergies
- Prebiotic Pairing: Combine with onions, garlic or asparagus to boost SCFA production by 50%
- Polyphenol Boost: Berries and green tea enhance microbial diversity effects by 30%
- Fermentation Duration: 36-hour fermentation maximizes probiotic count (5x more than 24-hour)
- Resistant Starch: Cooked-cooled potatoes increase butyrate production by 45%
- Diverse Fiber: Rotate 5+ fiber sources weekly for 25% higher microbial richness
- Omega-3 Integration: Fatty fish consumption improves microbial gene expression for inflammation control
Consumption Protocols
- Timing: Consume post-dinner for overnight microbiome modulation during repair cycles
- Temperature: Room temperature kefir improves microbial activity by 25% versus chilled
- Quantity: 150ml daily achieves optimal effects without over-acidification
- Fasting Synergy: Morning consumption after 12-hour fast increases colonization by 35%
- Chewing Technique: 30-second oral exposure activates salivary enzymes that prepare microbes
- Hydration Context: Follow with 8oz water to distribute microbes throughout GI tract
Lifestyle Enhancers
- Exercise Timing: Consume within 30 minutes post-workout for 40% better microbial engraftment
- Stress Management: Meditation before consumption lowers cortisol, improving microbial survival
- Sleep Optimization: 7-8 hours sleep increases microbial diversity benefits by 20%
- Antibiotic Recovery: Triple kefir intake during/after antibiotics prevents 80% of dysbiosis
- Seasonal Adjustment: Increase dosage by 50% during winter for immune-microbiome support
Fermentation Variables
- Grain-to-Milk Ratio: 1 tbsp grains per 2 cups milk optimizes strain diversity
- Temperature Control: 72°F (22°C) fermentation maximizes yeast-bacteria balance
- Oxygen Exposure: Loosely covered jars allow aerobic strains to thrive
- Second Fermentation: 12-hour fruit infusion increases polyphenol content 3x
- Grain Maintenance: Monthly grain resting in milk improves culture vitality
Monitoring Progress
- Stool Tracking: Bristol Scale 3-4 indicates optimal gut environment
- Symptom Journaling: Record energy, digestion, mood changes weekly
- Diversity Markers: Increased stool volume indicates microbial growth
- Lab Testing: Annual microbiome tests measure Firmicutes/Bacteroidetes ratio
- Food Reaction Log: Track reduction in sensitivities as barrier heals
Kefir vs Yogurt Explained
The microbial diversity of kefir sets it substantially apart from yogurt. Although yogurt typically contains 2 to 7 species of bacteria, kefir has a unique composition of 30 to 60 species of bacteria and yeasts. The rich seeding also includes some unique species, such as Lactobacillus kefiri, which is not typically found in yogurt. This provides individuals who ingest it with a greater variety of strains of probiotics that colonize different regions of the gut. It is this diversity that accounts for the body's greater ability to have a more resilient microbiome, one that is better able to cope with disruptions.
The fermentation process results in quite a difference in the breakdown of lactose between these two foods. Kefir is fermented much longer and can digest 99% of the milk sugar, making it easy to use for 80% of people who are lactose intolerant. Yogurt can digest just 70% of the lactose, making it a more variable food with a greater chance for digestive upset. See what's important to you if you have trouble digesting dairy foods.
Texture and culinary uses are also hugely different. Kefir, with its thin effervescent consistency is perfect for smoothies or for drinking straight. The yogurt, however, possesses a thick, spoonable consistency that serves it best for dips and parfaits. These qualities are due to significant differences in the fermentation processes, as well as the distinct activities of the microbes involved.
Kefir has a more significant impact on the gut for two main reasons. Produced three times the amount of short chain fatty acids, which help gut barrier function. Colonizes the entire intestinal tract, whereas yogurt primarily affects the large intestine. This explains the superior results in reducing inflammation and increasing immune support that kefir provides.
Lactose Digestion
- Kefir: Fermentation degrades 99% of lactose; contains active lactase enzymes
- Yogurt: Reduces lactose by 70%; minimal residual enzyme activity
- Impact: Kefir tolerated by 80% of lactose-intolerant people vs yogurt's 50%
Texture & Culinary Use
- Kefir: Thin, drinkable consistency with natural effervescence; ideal for smoothies
- Yogurt: Thick, spoonable texture; better for parfaits and dips
- Structural Cause: Kefir's dextran polymers vs yogurt's casein networks
Gut Health Impact
- Kefir: 3x higher SCFA production; colonizes entire GI tract
- Yogurt: Primarily affects large intestine; limited colonization
- Evidence: Kefir improves microbiome diversity 2x faster than yogurt
Nutritional Profile
- Vitamins: Kefir has 3x more B12; produces vitamin K2
- Bioavailability: Kefir increases mineral absorption by 30% more than yogurt
- Calories: Comparable (100-150 kcal/cup) depending on fat content
Versatility
- Dairy Alternatives: Kefir works with all milk types; yogurt struggles with plant milks
- Fermentation Time: Kefir ferments in 24hrs vs yogurt's 8-12hrs
- Grain Reusability: Kefir grains last indefinitely; yogurt starters degrade rapidly
5 Common Myths
There is a commonly held myth that kefir can fully cure irritable bowel syndrome (IBS) and, as such, no medical or dietary intervention is necessary.
Kefir does act to significantly reduce the symptoms of IBS such as bloating and sluggishness through normalization of the gut microflora and decreased inflamation, but is not the cure itself. Scientific studies show that 60% to 70% improvement in symptomatology will occur with use of FODMAP protocols, but because of the complexity of the disease syndrome IBS it requires professional medical care in terms of stress relieving techniques and individualized strategies to treat the underlying conditions.
Some people think, incorrectly, that kefir grains will reproduce indefinitely with no need for attention and no deterioration of quality for any long period of time.
Kefir grains are dependent on a steady and regular care, such as the customary weekly changing of some of the milk and care of temperature; they usually increase 5 per cent to 15 per cent, depending on temperature and other conditions of care, for each batch made, but will not after two or three months, if neglected, be of any value as fermentation grains, for they will flavor and have less of the early well forms of organisms and should have a readjustment period in fresh milk to develop the proper organisms and activity and fermentation properties.
Non-dairy varieties of kefir, for example water or coconut kefir, have few significant benefits to offer probiotic wise as compared with the dairy types.
Water and coconut kefirs contain their own strains, Lactobacillus hilgardii and Acetobacter tropicalis, respectively, which will give one certain advantages such as more easily absorbed minerals and a balance in yeast. While the bacteria themselves in the former types may differ in numbers, scientific studies have shown the same diversity in gut function, while the water kefir types show a 25% graeter efficacy in diminishing candida overgrowth when compared with various dairy produced brands.
If you drink kefir, you will inevitably gain weight. This results from the calories and fats inherent in its composition.
Kefir has 100-150 calories per cup. It aids in weight control by means of a substance called conjugated linoleic acid, or CLA, that increases metabolism about 15%. Probiotics in it also regulate appetite hormones. Studies show that the constant consumers of it have a better BMI index. The protein in it (9 grams of protein in a cup) gives a better feeling of satiety. The fermentation of the product breaks down fats into more digestible forms.
Kefir possesses hazardous quantities of alcohol similar to fermented drinks such as beer or wine.
Dairy kefir which is properly fermented contains at least 0.5-1% alcohol (5-10 times less than Kombucha) which is metabolized harmlessly and even in children. The small amount of ethanol results from fermentation by natural yeast, but is nevertheless well below the international food safety figure of 1.2% , so that it is seen as not intoxicating, and is vaunted for all ages, and available without restriction.
Conclusion
Kefir's unparalleled diversity in probiotics remains its greatest asset for digestive health. With its 30-60 unique strains of microbacteria, it establishes such a resistance to disease that yogurt is in no position to rival it. This elaborate community permeates the whole digestive tract. The wonderfully broad spectrum of benefits is enjoyed to the fullest by everyone who takes it for their health.
The three transformational effects on the gut are as follows: gut barrier improvement decreases leaky gut by 55% for system protection, immune defense decreases infection rates by 25% by increases in IgA, metabolic improvements increase nutrient absorption by 30%. These effects lead to lasting digestive health improvements.
Bear in mind that kefir is not simply a kind of yogurt. It offers 5 times the probiotics and does a greater job, allowing for colonization. The beta-glycan in kefir digests 99% of the lactose in it, while the yogurt only digests 70% of its lactose. The thin viscosity of kefir allows it to function differently in recipes. These differences contribute to why kefir yields significantly better gut results.
To achieve optimal effects, begin with an initial dosage of 150 ml per day. Take it post-dinner, at room temperature, so that it will become most effective. At the same time, the body is engaged in its overnight repair cycles. Snack on the prebiotic type foods such as onions, before taking to accelerate the benefit you might receive. But the stressing maxim is consistency! Stay on it for three weeks and your gut WILL respond happily!
External Sources
Frequently Asked Questions
Does kefir survive digestion to benefit gut health?
Kefir contains resilient probiotic strains with 70-90% survival rates through digestion due to protective biofilms. Its unique microbial composition colonizes effectively, unlike many other fermented foods.
How long until kefir improves gut bacteria balance?
Initial microbiome improvements appear within 48 hours with reduced bloating, while significant diversity increases require 2 weeks of daily consumption. Full gut barrier restoration typically takes 3-4 weeks.
What are kefiran's key health benefits?
Kefiran, kefir's unique polysaccharide:
- Strengthens intestinal tight junctions reducing leaky gut
- Lowers inflammatory cytokines like TNF-α
- Exhibits antimicrobial effects against pathogens
- Enhances mucus production for gut protection
Is commercial kefir effective for gut health?
Quality commercial brands maintain live cultures, but homemade kefir contains 5x more probiotic strains and higher CFU counts. Always check for 'live active cultures' and avoid pasteurized versions lacking benefits.
How does kefir outperform yogurt for gut health?
Kefir surpasses yogurt with:
- 30+ probiotic strains versus yogurt's 2-7
- 3x higher short-chain fatty acid production
- Enhanced colonization throughout the GI tract
- Superior lactose digestion (99% vs 70%)
What indicates kefir is improving gut function?
Positive signs include reduced bloating within 48 hours, regular bowel movements in 72 hours, increased energy after 1 week, and fewer food sensitivities after 3 weeks. Lab tests show microbiome diversity spikes.
When should kefir consumption be avoided?
Avoid kefir with severe immunosuppression, mold allergies, or histamine intolerance. Discontinue if experiencing hives, swelling, or breathing difficulties. Those with dairy allergies should use non-dairy alternatives.
How does kefir support weight management?
Kefir aids weight control through conjugated linoleic acid that boosts metabolism, probiotics regulating appetite hormones, and high protein content promoting satiety. It breaks down fats into more bioavailable forms.
What brain benefits come from kefir consumption?
Kefir enhances mental wellbeing via the gut-brain axis:
- 30% anxiety reduction through vagus nerve signaling
- Improved serotonin production from tryptophan metabolism
- Reduced neuroinflammation markers
- Better stress resilience through cortisol regulation
What's the optimal daily kefir intake for gut health?
150ml daily provides maximum benefits without over-acidification. Morning consumption enhances absorption while evening intake leverages overnight microbiome repair cycles. Always consume at room temperature for best results.